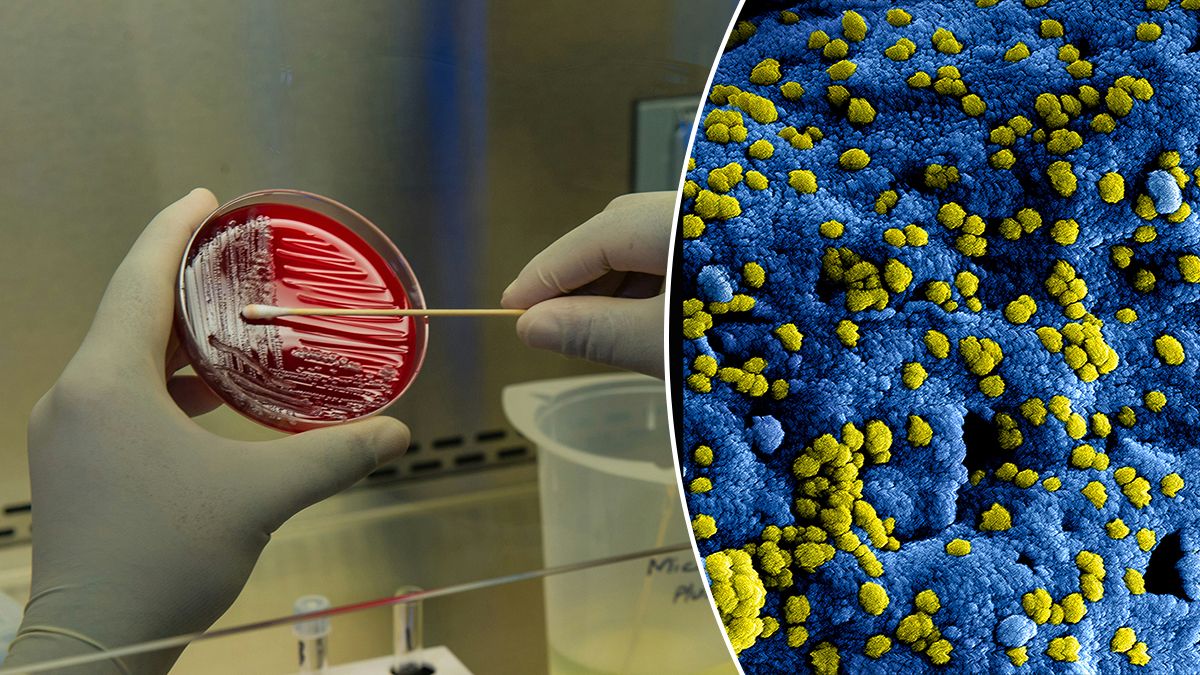
Как появилась жизнь на Земле – Ученые применяют новый метод для поиска начала всего Как появилась жизнь на Земле – Ученые применяют новый метод для поиска начала всего

В чем заключается новая идея?
В основе всей современной жизни лежит циклический процесс с участием двух типов полимеров: нуклеиновых кислот и белков. Понимание того, как эти структуры могли возникнуть путем неферментативного синтеза и объединиться в протоклетки, является ключевым для разгадки тайны происхождения жизни. Гипотеза "мира РНК" предполагает, что первые живые системы использовали этот полимер одновременно и для сохранения генетической информации, и как катализатор для ускорения химических реакций, пишет 24 Канал.
Смотрите также Новое царство на дереве жизни: ученые открыли организм, который не вписывается ни в какие классификации
Идея исследовать вулканические гидротермальные поля как колыбель жизни возникла во время экспедиции к вулкану в 2004 году. В горячей кислотной воде с температурой около 80 градусов Цельсия наблюдались интересные химические превращения. Например, добавленная к воде миристиновая кислота за считанные минуты образовывала белую пену вокруг краев бассейна – это было прямое свидетельство самосборки мембранных везикул в естественных условиях, имитирующих древнюю Землю.
Главным механизмом синтеза полимеров стали так называемые циклы увлажнения и высыхания. Когда вода в небольших бассейнах испаряется, растворенные в ней мономеры концентрируются и формируют тонкую органическую пленку на поверхности минералов. В процессе дегидратации (конденсации) молекулы воды вытесняются, что приводит к образованию эфирных связей, которые соединяют мономеры в длинные цепи нуклеиновых кислот. Это фактически обратный процесс к гидролизу, который обычно расщепляет полимеры в водной среде.
Секвенирование ДНК по-новому
Для проверки этой теории был применен революционный метод – нанопорное секвенирование, которое коллектив авторов описал в журнале Astrobiology. Сначала ученые использовали биологическую пору альфа-гемолизин, которая создает канал диаметром всего 2 нанометра в липидной мембране. Приложенное напряжение в 120 милливольт вызывает движение ионов калия и хлора через пору, создавая ионный ток силой примерно 120 пикоампер. Когда сквозь такой канал проходит одиночная молекула нуклеиновой кислоты, она блокирует до 90 процентов тока.
Продолжительность и амплитуда этих блокад дают бесценную информацию о молекуле: ее длину, состав нуклеотидных оснований и даже внутреннюю динамику, например развертывание спиралей. Хотя первые поры позволяли анализировать только гомополимеры, современные секвенаторы, такие как PromethION, способны различать все четыре типа оснований с точностью 99,75 процента.
Это настоящий технологический прорыв, учитывая, что первый геном человека секвенировали в течение 13 лет усилиями 20 лабораторий, потратив на это 2 миллиарда 700 миллионов долларов. Сегодня же тот же объем работы выполняется чуть более чем за 5 часов.
Прорывной результат
Эксперименты подтвердили, что многократное повторение циклов увлажнения и высыхания позволяет синтезировать олигомеры длиной от 10 до более 100 нуклеотидов без участия каких-либо ферментов. Использование масс-спектрометрии и современного секвенирования позволило окончательно отбросить сомнения скептиков, доказав, что полученные цепи являются настоящими молекулами ДНК и РНК.
Интересно, что смеси различных нуклеотидов иногда не просто смешиваются, а сортируются в специфические гомополимерные последовательности, что дает подсказки относительно химических механизмов ранней эволюции.
Вызовы
Одним из вызовов для такого синтеза является повреждение нуклеотидов в горячей кислой среде. Например, дезоксиаденозинмонофосфат теряет до 80 процентов своей структуры всего за два цикла из-за процесса депуринизации.
Однако наличие липидов действует как защита, практически полностью останавливая разрушение молекул. Это создает условия для "гонки со временем", где скорость синтеза полимеров должна превышать скорость их распада до установления динамического равновесия.
Что это нам дает?
В будущем нанопорный анализ может стать ключевым инструментом для поиска жизни на других планетах. Если на раннем Марсе существовали условия, подобные земным, марсианская жизнь могла оставить после себя полимеры, похожие на нуклеиновые кислоты.
Использование твердотельных нанопор, пробуренных в синтетических мембранах, позволит создать выносливые приборы, способные выдержать перелет через космос и жесткую посадку. Такие устройства могли бы искать линейные полианионы в образцах льда, скрытых под поверхностью Марса, что стало бы окончательным подтверждением параллельного развития жизни на двух планетах.